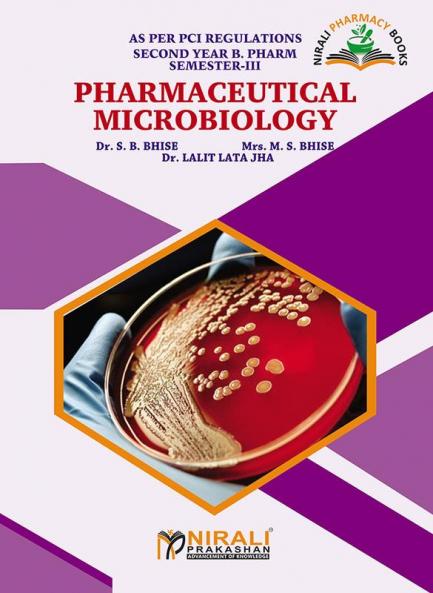

Paperback
₹175
(All inclusive*)
Delivery Options
Please enter pincode to check delivery time.
*COD & Shipping Charges may apply on certain items.
Review final details at checkout.
Looking to place a bulk order? SUBMIT DETAILS
Delivery Options
Please enter pincode to check delivery time.
*COD & Shipping Charges may apply on certain items.
Review final details at checkout.
About The Book
Description
Author
Pharmaceutical Microbiology by Dr.S.B.Bhise M.S.Bhise Dr.Lalit Lata Jha published by Nirali Prakashan stands as a beacon of knowledge and inspiration. With its insightful content and engaging narrative style this book transcends genres offering something valuable for every reader.
Details
ISBN 13
9789388897754
Publication Date
-01-04-2023
Pages
-158
Weight
-218 grams
Dimensions
-177.8x241.3x6.69 mm